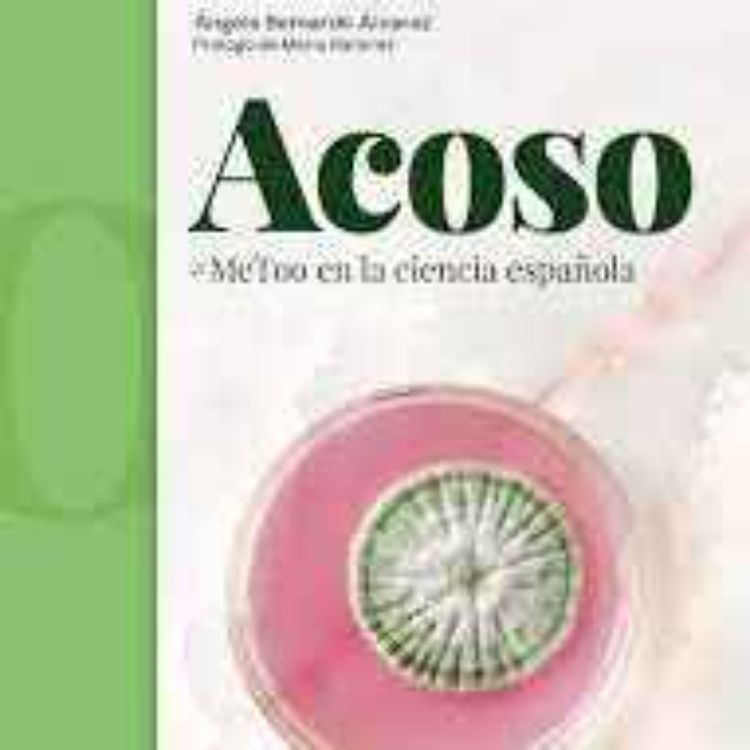
cover art for Acoso: #MeToo en la ciencia española

Share
Cómo ser feministas y no morir en el intento
Acoso: #MeToo en la ciencia española
Este Podcast es un episodio que forma parte de la serie “COMO SER FEMINISTAS Y NO MORIR EN EL INTENTO”, iniciativa dentro del Grado en Enfermería de la Universidad de Málaga, que pretende divulgar contenidos en materia de Género desde una perspectiva feminista. Ha sido elaborado por Alejandro Fama Arias, alumno de 2º curso del Grado en Enfermería (curso académico 22-23).
Esta obra se dedica a describir los numerosos casos de acoso sexual a lo largo de la historia centrados principalmente en el mundo de la ciencia y la docencia. Aborda también como han ido evolucionando diversos temas como el propio concepto de acoso sexual en el ámbito jurídico y social, la discriminación e igualdad de género y el más importante, el movimiento #MeToo. Este movimiento se centra en darle voz a todas las personas que han sufrido cualquier tipo de acoso sexual en su vida y que, por un motivo o por otro, no lo han denunciado. Además cuenta con numerosos estudios y encuestas realizadas por expertos que ayudan a definir y dar visión a la sociedad sobre la importancia de afrontar el acoso sexual.
More episodes
View all episodes

10. Biografía: María Montessori
07:41||Season 1, Ep. 10Este Podcast es un episodio que forma parte de la serie “COMO SER FEMINISTAS Y NO MORIR EN EL INTENTO”, iniciativa dentro del Grado en Enfermería de la Universidad de Málaga, que pretende divulgar contenidos en materia de Género desde una perspectiva feminista. Ha sido elaborado por Kichura Oksana, alumna de 2º curso del Grado en Enfermería (curso académico 22-23).María Montessori fue una mujer que en un ámbito de hombres y sin ninguna referente, se abrió paso en el mundo de la educación de los niños, con grandes y radicales cambios en la enseñanza.
2. ¿Quién le hacía la cena a Adam Smith?
06:58||Season 1, Ep. 2Este Podcast es un episodio que forma parte de la serie “COMO SER FEMINISTAS Y NO MORIR EN EL INTENTO”, iniciativa dentro del Grado en Enfermería de la Universidad de Málaga, que pretende divulgar contenidos en materia de Género desde una perspectiva feminista. Ha sido elaborado por Raúl Rodríguez Díaz, alumno de 2º curso del Grado en Enfermería (curso académico 22-23).En este libro se analiza el pasado de la economía y el pensamiento económico desde una perspectiva feminista. Se quiere desmontar la teoría del padre de la economía moderna, Adam Smith. Este escribió que cuando cenaba no tenía la carne o el pan por benevolencia del carnicero o del panadero, si no que la comida se encontraba en su mesa por el propio bienestar de los mismos. Esto explica el ánimo de lucro, naciendo así el Homo economicus. Sin embargo, Adam Smith, se llevaba algo a la boca porque su madre le preparaba la cena. Acto que no se hacia por interés propio, si no por puro amor hacia su hijo. ¿Quién paga este trabajo de criar, cuidar, limpiar y cocinar? Hoy, el centro de la economía es el interés propio y no hay ninguna motivación más. Ha llegado el momento de cambiar esto.
1.1. #madresarrepentidas
06:56||Season 1, Ep. 1.1Este Podcast es un episodio que forma parte de la serie “COMO SER FEMINISTAS Y NO MORIR EN EL INTENTO”, iniciativa dentro del Grado en Enfermería de la Universidad de Málaga, que pretende divulgar contenidos en materia de Género desde una perspectiva feminista. Ha sido elaborado por Chloe Rachael Woods, alumna de 2º curso del Grado en Enfermería (curso académico 22-23).“#madres arrepentidas” es un ensayo social que muestra la dura realidad de la maternidad con las experiencias reales de numerosas madres israelíes, sin tapujos y al desnudo. Desmiente el tabú de ser madre y destruye las construcciones sociales sobre una maternidad perfecta. Este libro revela a través de experiencias reales cómo las mujeres que son madres sufren tanta presión que solo ven a sus hijos e hijas como una carga.
30.1. Mamá quiero ser feminista
06:45||Season 1, Ep. 30.1Este Podcast es un episodio que forma parte de la serie “COMO SER FEMINISTAS Y NO MORIR EN EL INTENTO”, iniciativa dentro del Grado en Enfermería de la Universidad de Málaga, que pretende divulgar contenidos en materia de Género desde una perspectiva feminista. Ha sido elaborado por María Vargas Jiménez, alumna de 2º curso del Grado en Enfermería (curso académico 22-23).En dicho libro, la autora comenta su vida en un pueblo sevillano, con las típicas costumbres de esa época, y en las que ella no se sentía identificada por lo que hizo todo lo posible para salir de allí, además de poder conseguir todo lo que su madre no pudo, por estar atada a una sociedad donde los estudios no estaban indicados para las mujeres, sino que tenían designadas otras actividades. En sus diferentes experiencias fuera de su pueblo, elaborando su formación, se dio cuenta de muchas cosas, como, por ejemplo: el concepto de feminismo, además de conocer la violencia por parte de los hombres hacia sus amigas, incluso casi el hecho de realizárselo a ella sus compañeros y amigos del piso. Finalmente, se dio cuenta que su vida no estaba fuera de allí, solo porque las anteriores generaciones no eran feministas, sino que ella podría vivir su vida como ella quisiera desde cualquier punto del mundo, y sabía perfectamente que su madre y su hermana pequeña eran sus puntos de apoyos principales.
18.1. Ética para Celia
08:55||Season 1, Ep. 18.1Este Podcast es un episodio que forma parte de la serie “COMO SER FEMINISTAS Y NO MORIR EN EL INTENTO”, iniciativa dentro del Grado en Enfermería de la Universidad de Málaga, que pretende divulgar contenidos en materia de Género desde una perspectiva feminista. Ha sido elaborado por Sofía Solís Melcon, alumna de 2º curso del Grado en Enfermería (curso académico 22-23).Este libro trata de motivar la aplicación de la ética y filosofía por parte de la población masculina para que se atrevan a transgredir la verdad con la que han nacido impuesta por los antecedentes de una sociedad patriarcal. L a ética nos invita a ponernos en el lugar de los demás , cosa que no ha sucedido históricamente por parte de los hombres hasta la actualidad . Gracias a la aportación de la ética y de la filosofía podemos comprender gran cantidad de contradicciones e injusticias con las que han tenido que lidiar las mujeres durante su existencia pero que gracias a esto se han cuestionado estas desigualdades y el sistema patriarcal que aun persiste en la actualidad. Desde los inicios , todo ha valido con nosotras, nos han humillado, violado , quitado el reconocimiento … es por eso que É tica para Celia busca que nos enfrentemos a la realidad que la que se nuestra vida se ha construid o bajo una doble verdad con normas vitales y morales que distan mucho de la igualdad entre hombre s y mujeres a pesar de que se ha trasformado, pero sigue existiendo actualmente.
6. Biografía: Agatha Christie
07:44||Season 1, Ep. 6Este Podcast es un episodio que forma parte de la serie “COMO SER FEMINISTAS Y NO MORIR EN EL INTENTO”, iniciativa dentro del Grado en Enfermería de la Universidad de Málaga, que pretende divulgar contenidos en materia de Género desde una perspectiva feminista. Ha sido elaborado por Laura Sánchez Muñoz, alumna de 2º curso del Grado en Enfermería (curso académico 22-23).Agatha fue una mujer inglesa adelantada a su época. Nació en un círculo familiar en el que se la educó con una libertad que no tenían las mujeres de entonces, lo que le permitió crecer aprendiendo sobre todo lo que le interesaba. Llegó a dominar la lectura, la escritura, la danza, el canto y el piano, la química y las matemáticas, la cerámica prehistórica y hasta el surf. Guiada por su espíritu aventurero, recorrió el mundo a lo largo de su vida, llenándose de millones de experiencias que la inspiraron en las creaciones de sus obras, convirtiéndose así en una de las escritoras que más novelas ha vendido en el mundo.
28. Los hombres me explican cosas
08:29||Season 1, Ep. 28Este Podcast es un episodio que forma parte de la serie “COMO SER FEMINISTAS Y NO MORIR EN EL INTENTO”, iniciativa dentro del Grado en Enfermería de la Universidad de Málaga, que pretende divulgar contenidos en materia de Género desde una perspectiva feminista. Ha sido elaborado por Paula Romero moreno, alumna de 2º curso del Grado en Enfermería (curso académico 22-23).‘’Los hombres me explican cosas’’ es un conjunto de ensayos en el que la autora refleja la desigualdad entre hombres y mujeres y sobre todo la violencia que siguen sufriendo las mujeres en la actualidad. Cuenta como los hombres alegan una superioridad sobre el género femenino, como las minimizan y maltratan porque realmente sienten que tienen un derecho sobre ellas, y tristemente cuenta como muchas mujeres normalizan y aceptan esta situación, ya que es lo que viven día a día.
39.1. SOS... mi chico me pega pero yo le quiero
07:25||Season 1, Ep. 39.1Este Podcast es un episodio que forma parte de la serie “COMO SER FEMINISTAS Y NO MORIR EN EL INTENTO”, iniciativa dentro del Grado en Enfermería de la Universidad de Málaga, que pretende divulgar contenidos en materia de Género desde una perspectiva feminista. Ha sido elaborado por Gladis Maribel Rodríguez López, alumna de 2º curso del Grado en Enfermería (curso académico 22-23).Este libro nos habla de muchos casos en los que una joven sufre violencia por su pareja. Donde nos puede ayudar a corregir muchos de los mitos, ideas erróneas que aún hoy en día existen sobre lo que se conoce como violencia de género, y descubrir las principales señales de alerta del inicio de una relación, que puede tener graves consecuencias para la salud psicológica, física y sexual de las personas afectadas. En este libro se pueden analizar algunos casos reflejados en los medios de comunicación de España y se incluyen testimonios de jóvenes que han superado positivamente el maltrato de pareja. Asimismo, el autor propone pautas para la prevención, un plan de autoprotección personal y de valoración del riesgo, y orientaciones sobre qué conviene hacer y no hacer en situaciones de maltrato, cuándo es necesario solicitar ayuda psicológica especializada y por qué es muy eficaz la asistencia a grupos de apoyo psicológico.
7. Biografía: Clara Campoamor
07:48||Season 1, Ep. 7Este Podcast es un episodio que forma parte de la serie “COMO SER FEMINISTAS Y NO MORIR EN EL INTENTO”, iniciativa dentro del Grado en Enfermería de la Universidad de Málaga, que pretende divulgar contenidos en materia de Género desde una perspectiva feminista. Ha sido elaborado por María Reina Borrego, alumna de 2º curso del Grado en Enfermería (curso académico 22-23).El libro es una biografía novelada de Clara Campoamor. A través de la lectura de los diferentes capítulos se recorre su vida desde su infancia hasta su muerte. Se destaca el hecho de que fue pionera en innumerables aspectos, desde el parlamento hasta el Tribunal Supremo pasando por cuantiosos puestos de trabajo que, en su época, “estaban reservados” para los hombres. No obstante, no solo se habla de sus logros, sino también, de todos los momentos trabajosos de su vida entre los que destaca la delicadísima situación de su economía familiar y sus exilios durante los cuales anhelaba enormemente su España natal.